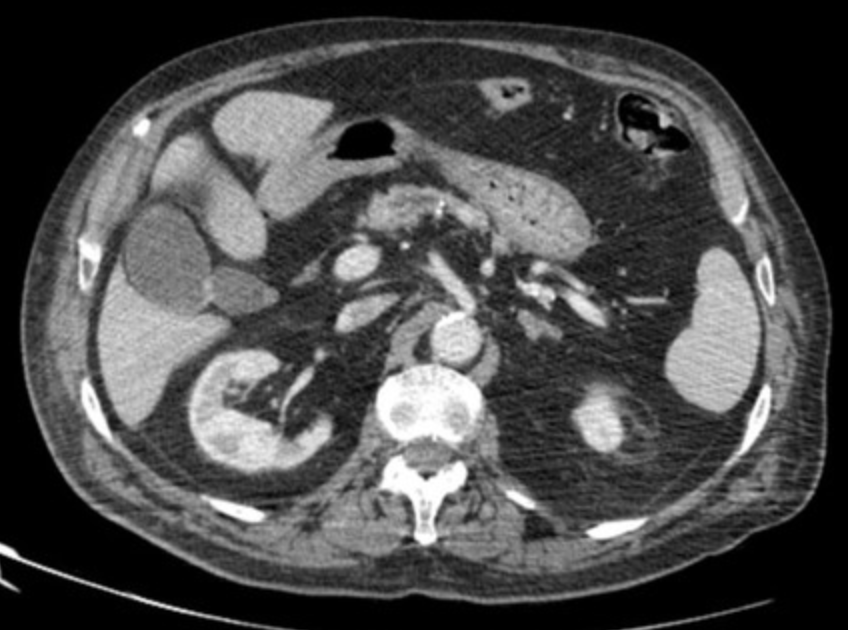

Gallbladder
Adenomyomatosis
Accumulation of cholesterol crystals in gallbladder with formation of GB wall out-pouchings called Rokitansky-Aschoff sinuses
Comet-tail artifact is highly suggestive of diagnosis
Looks like a dot with streaky line following it
3 types - doesnt really matter although
Hourglass gallbladder = cholesterol granules and sinuses accumulate symmetrically on each side of GB wall pushing the walls inward to look like an hourgalass
Seen in segmental form

Biliary Ductal dilatation
On US can differentiate from vessels by putting on doppler
Biliary ducts will have no flow
Dilatation
>2mm for intrahepatic ducts
>6mm for extrahepatic ducts
> 10mm (1.0 cm) for extrahepatic ducts if had cholecystectomy
Hepatolithiasis
Stone in intrahepatic biliary duct
Causes
Primary sclerosing cholangitis
Recurrent pyogenic cholangitis
Biliary anastomosis
Primary Sclerosing cholangitis
Multifocal structures of the intra and extrahepatic biliary ducts
Increased risk for cholangiocarcinoma
Associated with ulcerative colitis
Findings
US
Biliary wall thickening
Biliary strictures
Pneumobilia
Air in biliary tree
Findings
US
Linear hyperechoic structures
Dirty shadowing
DDX
Recent procedure
Sphincter of Oddi dysfunction/incompetence
Fistula
Infection

Acute Cholecytitis
Dilation, inflammatory changes of the GB
Tensile Gallbladder Wall sign
Distended GB causes mass effect on the abdominal wall causing the abdominal wall to bow outward
Klatskin Tumor (Hilar Cholangiocarcinoma)
Typically at bifurcation of common bile duct
Findings
Intrahepatic biliary ductal dilation
Mass at liver hilum
Emphysematous Cholecystitis
Technically a form of pneumobilia but has a specific sign
Champagne sign
Looks like ill defined bubbles about the GB wall, typically in anti-dependent portion
Does not always have strong dirty shadowing
Association with diabetes
Surgical emergency

Choledochal Cysts
5 Flavors
Type 1
Most common
1A - diffuse - involve entire extrahepatic biliary ducts
1B - focal - involve segment of extrahepatic biliary duct
1C - fusiform - only affect CBD
Type 2
Extrahepatic biliary duct diverticula
Type 3
Choledococele = ectasia of CBD segment
Type 4
Multiple intrahepatic and extrahepatic aspects
Type 5
Caroli disease = congenital cystic dilatation of the intrahepatic biliary ducts
Biliary Cystadenocarcinoma
Multiseptate liver mass
Proteinacous fluid content better seen on MR than CT (see different signal on MR not seen on CT basically)
Cannot really be differentiated fro biliary cystadenoma on imaging alone
Nodularity of septa suggests malignancy



Cholangiocarcinoma
Painless jaundice with normal pancreatic duct
Can obstruct the CBD from intraluminal mass without any real adjacent soft tissue mass or irregularity
Honestly seems pretty vague and broad with a bunch of different types but the items that seem to share are
Fucked up looking liver/ biliary tree
Fibrosis - mass stays enhancing on delayed imaging
Capsular retraction
Biliary ducts get fucked too, probably dilated even if not severe



References: